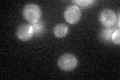
YOR236W
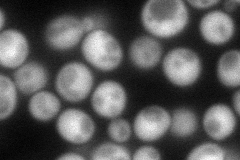
YOR236W
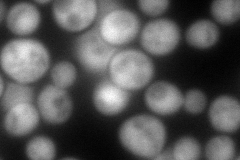
YOR236W
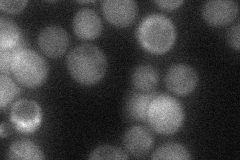
YOR236W
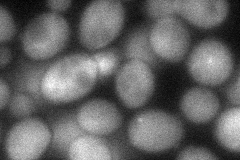
YOR236W
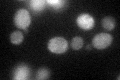
YOR236W
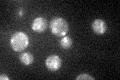
YOR236W

View description
Dihydrofolate reductase, part of the dTTP biosynthetic pathway, involved in folate metabolism, possibly required for mitochondrial function
Localization:
Intensity:
Fold change:
Significance:
-
C’ GFP library in SD
mitochondria36.26 -
N' NOP1pr-GFP in SD
cytosol121.149 -
N' TEF2pr-mCherry in SD
cytosol173.602 -
N' NATIVEpr-GFP in SD
cytosol36.393 -
N' TEF2pr-VC and Cyto-VN in SD
cytosol54.9881 -
C’ GFP library in SD+DTT
mitochondria48.961.34Yes -
C’ GFP library in SD+H2O2

mitochondria30.680.84No -
C’ GFP library in Starvation Media
mitochondria43.61.2No -
C’ GFP library on the background of Pup2-DaMP

mitochondria -
C’ GFP library on the background of CCT mutant

mitochondria33.44760.92221No
